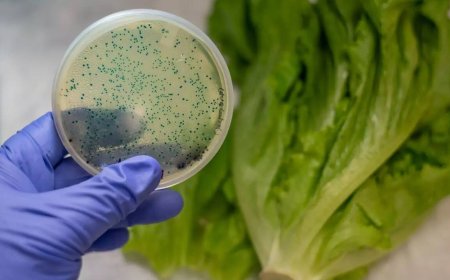
6 kitchen mistakes that could expose you to harmful E. coli and cause serious infections

Sagar Chauhan
Sagar Chauhan, the founder of CRM Techie, is passionate about sharing insights and expertise across a broad spectrum of topics, including business, entertainment, technology, sports, lifestyle, and environment. With a deep commitment to staying at the forefront of industry trends, Sagar's blog is designed to deliver valuable content that resonates with a diverse audience.
In the business category, Sagar offers strategic advice and practical tips that empower entrepreneurs and professionals to excel in their fields. His experience in digital marketing and business innovation shines through, providing readers with actionable insights that drive growth and success.
Sagar's interest in entertainment is reflected in his exploration of the latest trends in film, music, and pop culture. He examines how entertainment intersects with technology and society, offering a unique perspective that keeps readers informed and engaged.
The technology section of Sagar's blog delves into the latest advancements and emerging trends, helping readers understand how these innovations are shaping the future. From AI to software development, Sagar's content is both informative and forward-thinking.
In sports, Sagar combines his passion for the game with in-depth analysis, covering everything from major events to the business side of sports. His writing appeals to both casual fans and industry insiders, offering something for everyone.
Sagar's focus on lifestyle explores the intersection of wellness, culture, and technology. His content encourages readers to lead balanced and fulfilling lives, with tips on everything from productivity to personal growth.
Finally, in the environment category, Sagar emphasizes the importance of sustainability and eco-friendly practices. He explores how technology can contribute to a greener future and offers insights into the latest environmental initiatives and trends.
With a professional tone and SEO-optimized content, Sagar Chauhan's blog is a trusted source of information and inspiration for anyone interested in these dynamic categories. Whether you're looking to stay ahead in business, discover the latest in entertainment, or learn about sustainable living, Sagar's blog provides the knowledge and insights you need.
 The Union Budget is a significant event in India. For kids, understanding the budget can provide valuable insights into how the country plans its finances and prioritizes various sectors. Here are a few interesting facts about the Indian Union Budget that kids should know:
The Union Budget is a significant event in India. For kids, understanding the budget can provide valuable insights into how the country plans its finances and prioritizes various sectors. Here are a few interesting facts about the Indian Union Budget that kids should know:  Like
0
Like
0
 Dislike
0
Dislike
0
 Love
0
Love
0
 Funny
0
Funny
0
 Angry
0
Angry
0
 Sad
0
Sad
0
 Wow
0
Wow
0